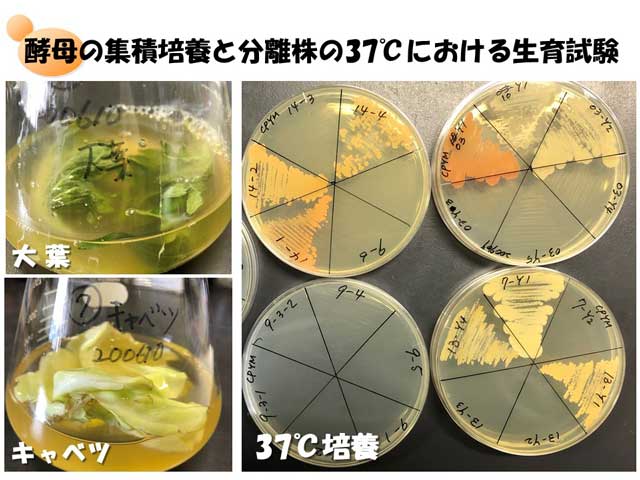
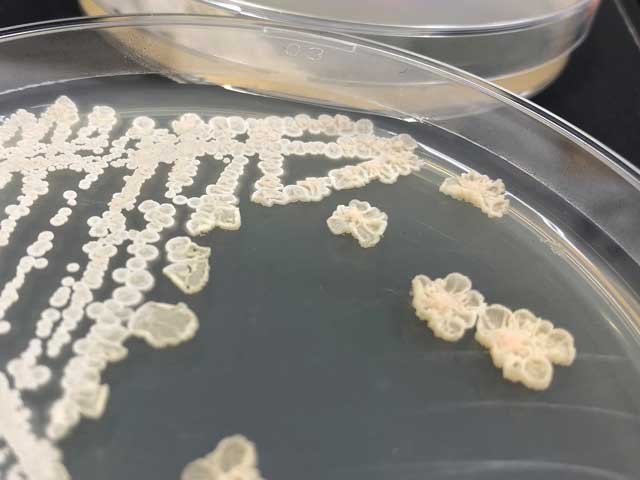

学部・学科・大学院
薬学科
永塚 由佳(ながつか ゆか)

| 職 名 | 講師 |
|---|---|
| 学 位 | 博士(工学) |
| 専門分野 | 微生物分類学、細菌学、真菌学 |
| 担当科目 | 病原体としての微生物、悪性腫瘍の薬・病態・治療、薬学総論、事前学習、実習Vなど |
| メッセージ | 感染症の原因菌は食品や自然環境などの身近な環境に棲息しており、その種類も教科書に載っている菌種に限らず多種多様です。ヒトに感染し病気を引き起こすかどうかは何で決まるのか?新たな感染症起因菌に最適な治療薬をいち早く選択し、治療するにはどうすれば良いのか?臨床における感染症の問題解決をともに目指しましょう! |
薬剤耐性菌はどこで発生する?どこからやって来る?
薬剤耐性菌の出現、多様化、蔓延化、高度耐性化は、感染症化学療法における大きな問題です。薬剤投与により体内の常在菌は簡単に耐性化するのでしょうか?それとも薬剤耐性菌は外界から体内に持ち込まれたのでしょうか?では、薬剤耐性菌はどこにいるのでしょうか?食品、河川水、土壌などの生活環境?私たちの身体にもひっそりと棲息しているのでしょうか?気になりますね。環境サンプルや生体サンプルより微生物を分離・同定し、薬剤感受性や病原因子を調べ、この謎に迫ります。
生野菜にも37℃で生育する酵母がいました!
病原性の有る無しは、何で決まるの?
感染症患者から分離された原因菌が教科書には載っていない菌種という事例が臨床現場では生じています。そして、それらの菌の多くは私たちの身の回りに棲息する一般環境微生物です。ではどんな特徴を持つ微生物が感染症を引き起こすのでしょうか?メジャーな病原菌において病原因子の研究が進められていますが、マイナーな病原菌の病原因子は不明です。多様化する様々な病原菌の病原因子を明らかにすることにより、潜在的に病原性を有する新たな病原菌の特定や、創薬の新たなターゲットの発見を目指します!
3年生が水菜から分離した酵母です。どんな種類?病原性は?





